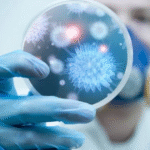

Според податоците од платежната статистика на Народната банка, и во првите три месеци од 2025 година граѓаните сѐ повеќе користат мобилни апликации и картички за да плаќаат, наместо да одат на шалтер и да користат хартиени налози.
Како што стои во соопштението на Народна банка, во споредба со истиот период лани, бројот на плаќањата со платни налози пораснал за 2,7 отсто, а вредноста за дури 17,7 проценти. Особено брзо растат електронските плаќања преку интернет или мобилен телефон коишто се зголемени за речиси 13 отсто по број и за над 30 проценти по вредност.
Најголемиот дел од електронските трансакции (над 70 отсто) се направени преку мобилни апликации, што покажува дека телефонот станува омилен начин за плаќање – брзо, едноставно и достапно. И употребата на платежните картички и натаму расте. Бројот на плаќањата со картички е зголемен за 1,1 проценти, а вредноста за 8,6 отсто. Овој раст најмногу се должи на зголеменото купување преку интернет (7,1 отсто), но има раст и кај плаќањата во продавниците (0,6 отсто), стои во соопштението.
Од Народна банка додаваат дека овие бројки од платежната статистика покажуваат дека сѐ повеќе граѓани се префрлаат на дигиталните начини на плаќање.